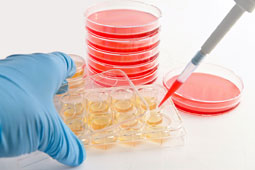

|
 Ορισμένα παθολογικά προβλήματα εμφανίζονται συνηθέστερα κατά τη διάρκεια του Φθινοπώρου. Τα προβλήματα αυτά συνηθέστερα είναι ήπια, που αναδύονται κατά τη διαδικασία προσαρμογής από τις διακοπές στη ρουτίνα Ορισμένα παθολογικά προβλήματα εμφανίζονται συνηθέστερα κατά τη διάρκεια του Φθινοπώρου. Τα προβλήματα αυτά συνηθέστερα είναι ήπια, που αναδύονται κατά τη διαδικασία προσαρμογής από τις διακοπές στη ρουτίνα |
|
Περισσότερα...
|
 Σε έρευνα που παρουσιάστηκε στο συνέδριο Πειραματικής Βιολογίας στη Βοστόνη βρέθηκε ότι οι πολυφαινόλες του σταφυλιού έχουν προστατευτικές ιδιότητες που προστατεύουν ζωτικά όργανα όπως το συκώτι, η καρδιά και τα νεφρά. Σε έρευνα που παρουσιάστηκε στο συνέδριο Πειραματικής Βιολογίας στη Βοστόνη βρέθηκε ότι οι πολυφαινόλες του σταφυλιού έχουν προστατευτικές ιδιότητες που προστατεύουν ζωτικά όργανα όπως το συκώτι, η καρδιά και τα νεφρά. |
|
Περισσότερα...
|
 Η κατάλληλη ηλικία για να ξεκινήσετε να παίρνετε το μικρό σας στη θάλασσα είναι περίπου στους 6 μήνες, αφού έχει ακόμα τα βιώματα από την κοιλιά της μαμάς του και δεν έχει ακόμα αναπτύξει το αίσθημα του φόβου. Η κατάλληλη ηλικία για να ξεκινήσετε να παίρνετε το μικρό σας στη θάλασσα είναι περίπου στους 6 μήνες, αφού έχει ακόμα τα βιώματα από την κοιλιά της μαμάς του και δεν έχει ακόμα αναπτύξει το αίσθημα του φόβου. |
|
Περισσότερα...
|
 Το σχήμα του ποτηριού παίζει σημαντικό ρόλο στο πόσο αλκοόλ θα καταναλώσει κανείς, σύμφωνα με μία νέα βρετανική έρευνα, που κατέληξε στο συμπέρασμα ότι οι άνθρωποι πίνουν αρκετά πιο πολύ από ποτήρια με καμπύλες που έχουν Το σχήμα του ποτηριού παίζει σημαντικό ρόλο στο πόσο αλκοόλ θα καταναλώσει κανείς, σύμφωνα με μία νέα βρετανική έρευνα, που κατέληξε στο συμπέρασμα ότι οι άνθρωποι πίνουν αρκετά πιο πολύ από ποτήρια με καμπύλες που έχουν |
|
Περισσότερα...
|
 Τί θα μπορούσατε να καταναλώσετε για να καταπολεμήσετε την πείνα σας στην παραλία ενώ παράλληλα να χαρίσετε στο σώμα σας ενέργεια και θρεπτικά συστατικά από σνακ και μικρογεύματα καλής ποιότητας; Τί θα μπορούσατε να καταναλώσετε για να καταπολεμήσετε την πείνα σας στην παραλία ενώ παράλληλα να χαρίσετε στο σώμα σας ενέργεια και θρεπτικά συστατικά από σνακ και μικρογεύματα καλής ποιότητας; |
|
Περισσότερα...
|
 Όμως όπως κι αν έχει, για να απολαύσετε τις διακοπές σας όσοι πάσχετε από καρδιακή ανεπάρκεια πρέπει να γνωρίζετε τα παρακάτω: Όμως όπως κι αν έχει, για να απολαύσετε τις διακοπές σας όσοι πάσχετε από καρδιακή ανεπάρκεια πρέπει να γνωρίζετε τα παρακάτω: |
|
Περισσότερα...
|
 Η ζωή σε παραθαλάσσιες περιοχές μπορεί να παρέχει ένα έξτρα όφελος: την καλύτερη υγεία. Αυτό είναι το συμπέρασμα μιας νέας μελέτης, στην οποία αναλύθηκαν στοιχεία από 48 εκατομμύρια κατοίκους της Αγγλίας. Η ζωή σε παραθαλάσσιες περιοχές μπορεί να παρέχει ένα έξτρα όφελος: την καλύτερη υγεία. Αυτό είναι το συμπέρασμα μιας νέας μελέτης, στην οποία αναλύθηκαν στοιχεία από 48 εκατομμύρια κατοίκους της Αγγλίας. |
|
Περισσότερα...
|
 Σε τοξικές παραλίες κάνουν μπάνιο οι κάτοικοι του Λαυρίου, με τις αρμόδιες αρχές να φέρουν τεράστια ευθύνη, αφού όχι μόνον δεν έχουν βάλει προειδοποιητικές πινακίδες, αλλά απεναντίας έχουν τοποθετήσει στις παραλίες ομπρέλες !!! Σε τοξικές παραλίες κάνουν μπάνιο οι κάτοικοι του Λαυρίου, με τις αρμόδιες αρχές να φέρουν τεράστια ευθύνη, αφού όχι μόνον δεν έχουν βάλει προειδοποιητικές πινακίδες, αλλά απεναντίας έχουν τοποθετήσει στις παραλίες ομπρέλες !!! |
|
Περισσότερα...
|
Μερικοί από αυτούς, οι οποίοι ήταν παράλυτοι, μπόρεσαν να ξαναπερπατήσουν, δήλωσαν οι βρετανοί επιστήμονες στο πρόγραμμα Panorama του BBC. Μερικοί από αυτούς, οι οποίοι ήταν παράλυτοι, μπόρεσαν να ξαναπερπατήσουν, δήλωσαν οι βρετανοί επιστήμονες στο πρόγραμμα Panorama του BBC. |
|
Περισσότερα...
|
 Η εξήγηση δεν βρίσκεται στην αϋπνία ή σε κάποια άλλη διαταραχή του ύπνου αλλά αποτελεί βασικό χαρακτηριστικό επιβίωσης, σύμφωνα με τους επιστήμονες. Η εξήγηση δεν βρίσκεται στην αϋπνία ή σε κάποια άλλη διαταραχή του ύπνου αλλά αποτελεί βασικό χαρακτηριστικό επιβίωσης, σύμφωνα με τους επιστήμονες. |
|
Περισσότερα...
|
 Έχετε γνωρίσει ποτέ ανθρώπους που φαίνεται να έχουν συνέχεια προβλήματα στη ζωή τους ή έχει συμβεί ποτέ σε εσάς τους ίδιους; Μια νέα έρευνα έδειξε ότι πολλά προβλήματα επιμένουν πεισματικά, ανεξάρτητα από το πόσο σκληρά δουλεύουν οι άνθρωποι για να τα διορθώσουν. Έχετε γνωρίσει ποτέ ανθρώπους που φαίνεται να έχουν συνέχεια προβλήματα στη ζωή τους ή έχει συμβεί ποτέ σε εσάς τους ίδιους; Μια νέα έρευνα έδειξε ότι πολλά προβλήματα επιμένουν πεισματικά, ανεξάρτητα από το πόσο σκληρά δουλεύουν οι άνθρωποι για να τα διορθώσουν. |
|
Περισσότερα...
|
 Το τι τρώμε και το πόσο τρώμε είναι γνωστό ότι επηρεάζουν την υγεία μας και ειδικότερα τις πιθανότητες ανάπτυξης ορισμένων από τις πιο συχνές μορφές καρκίνου, όπως ο καρκίνος του παχέος εντέρου. Το τι τρώμε και το πόσο τρώμε είναι γνωστό ότι επηρεάζουν την υγεία μας και ειδικότερα τις πιθανότητες ανάπτυξης ορισμένων από τις πιο συχνές μορφές καρκίνου, όπως ο καρκίνος του παχέος εντέρου. |
|
Περισσότερα...
|
 Κάθε χρόνο που περνάει τα κουνούπια μοιάζουν να είναι ανθεκτικότερα από τον προηγούμενο. Τι φιδάκια, τι παστίλιες, τι πασαλείμματα με αντικουνουπικά, εκείνα θα τσιμπήσουν. Κάθε χρόνο που περνάει τα κουνούπια μοιάζουν να είναι ανθεκτικότερα από τον προηγούμενο. Τι φιδάκια, τι παστίλιες, τι πασαλείμματα με αντικουνουπικά, εκείνα θα τσιμπήσουν. |
|
Περισσότερα...
|
 Το ΕΚΑΒ ενημερώνει. Τι να κάνετε εάν σας τσιμπήσει σφήκα, μέλισσα, σας χτυπήσει δράκαινα, σαλάχι, σκυλόψαρο, καθώς kai για προβλήματα μέσα στη θάλασσα. Το ΕΚΑΒ ενημερώνει. Τι να κάνετε εάν σας τσιμπήσει σφήκα, μέλισσα, σας χτυπήσει δράκαινα, σαλάχι, σκυλόψαρο, καθώς kai για προβλήματα μέσα στη θάλασσα.
|
|
Περισσότερα...
|
 Η λεγιονέλλα είναι ένα βακτήριο ευρέως διαδεδομένο στη φύση. Υπάρχει στα περισσότερα συστήματα νερού και αποικίζει εύκολα όλα τα συστήματα ύδρευσης και τα δίκτυα παροχής θερμού και κρύου νερού. Η λεγιονέλλα είναι ένα βακτήριο ευρέως διαδεδομένο στη φύση. Υπάρχει στα περισσότερα συστήματα νερού και αποικίζει εύκολα όλα τα συστήματα ύδρευσης και τα δίκτυα παροχής θερμού και κρύου νερού. |
|
Περισσότερα...
|
|
|
|
|
JPAGE_CURRENT_OF_TOTAL |